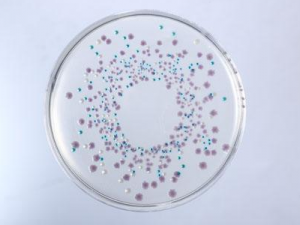
6��ˮ����Ʒ����ֵ�ϸ� �󳦾�Ⱥ�����к�Σ��

灵芪养心口服液的功效与作用、食用方法和简介
来源:互联网搜集 时间:2012-08-06 13:43 编辑:admin 手机版访问
导读:·产品名称:灵芪养心口服液·产品分类:药品/中成药/肾系病症·英文名称:·批准文号:国药准字B20020570·主要规格:每支装10ml...
·产品名称:灵芪养心口服液
·产品分类:药品/中成药/肾系病症
·英文名称:
·批准文号:国药准字B20020570
·主要规格:每支装10ml
·产品分类:药品/中成药/肾系病症
·英文名称:
·批准文号:国药准字B20020570
·主要规格:每支装10ml
热点排行
-
 台湾枸杞菜的营养价值及功效与作用 台湾枸杞菜,能清肝明目,滋阴润燥,止咳化痰,是一种去秋燥的上品青菜! … [详情]
台湾枸杞菜的营养价值及功效与作用 台湾枸杞菜,能清肝明目,滋阴润燥,止咳化痰,是一种去秋燥的上品青菜! … [详情] -
 巴西红果的营养价值及功效作用 巴西红果别名红果仔,肉厚多汁,营养价值丰富,有止痛安神,对于肿痛等问题 … [详情]
巴西红果的营养价值及功效作用 巴西红果别名红果仔,肉厚多汁,营养价值丰富,有止痛安神,对于肿痛等问题 … [详情] -
 荷包豆的营养价值 荷包豆的功效与作用 荷包豆因外形似荷包而得名,有着很好的祛湿、补血、健胃的功效!常吃荷包豆 … [详情]
荷包豆的营养价值 荷包豆的功效与作用 荷包豆因外形似荷包而得名,有着很好的祛湿、补血、健胃的功效!常吃荷包豆 … [详情] -
 牛骨的营养价值 牛骨煲汤搭配什么最好 牛骨是一种食材,营养价值丰富,牛骨煲汤搭配什么最好呢?
… [详情]
牛骨的营养价值 牛骨煲汤搭配什么最好 牛骨是一种食材,营养价值丰富,牛骨煲汤搭配什么最好呢?
… [详情] -
 小芒果的营养价值 小芒果的作用功效详解! 小芒果是我们生活中很常见的一种水果,因为小芒果它那独特的酸酸甜甜的口味 … [详情]
小芒果的营养价值 小芒果的作用功效详解! 小芒果是我们生活中很常见的一种水果,因为小芒果它那独特的酸酸甜甜的口味 … [详情]
热门推荐
好文阅读
-
 牙签豆皮卷的做法 牙签豆皮卷怎么做好吃 牙签豆皮卷是一道美味的食谱,营养价值丰富,牙签豆皮卷的做法有哪些?牙签 … [详情]
牙签豆皮卷的做法 牙签豆皮卷怎么做好吃 牙签豆皮卷是一道美味的食谱,营养价值丰富,牙签豆皮卷的做法有哪些?牙签 … [详情] -
 人们日常如何正确养肝 日常养肝的饮食原则 当酒精进入身体之后,经过分解之后会产生乙醇代谢物,此种代谢物会肝脏极其 … [详情]
人们日常如何正确养肝 日常养肝的饮食原则 当酒精进入身体之后,经过分解之后会产生乙醇代谢物,此种代谢物会肝脏极其 … [详情] -
 防犀饮的功效 防犀饮主丹疹遍身如洒珠者 方剂剂型:汤剂、丸剂、散剂、膏剂、丹剂、酒剂、药酒、冲剂、口服液剂、胶 … [详情]
防犀饮的功效 防犀饮主丹疹遍身如洒珠者 方剂剂型:汤剂、丸剂、散剂、膏剂、丹剂、酒剂、药酒、冲剂、口服液剂、胶 … [详情] -
 越婢汤的功效 越婢汤治疗哮喘 越婢治水水因风,里热需用石膏清, 麻黄甘草鲜姜枣,卒然浮肿最灵通。 … [详情]
越婢汤的功效 越婢汤治疗哮喘 越婢治水水因风,里热需用石膏清, 麻黄甘草鲜姜枣,卒然浮肿最灵通。 … [详情] -
6种水果样品菌落值较高 大肠菌群过高有何危害 实验技术人员介绍,夏日气温较高,新鲜切开的西瓜滋生细菌量较高,因此检测 … [详情]
6种水果样品菌落值较高 大肠菌群过高有何危害 实验技术人员介绍,夏日气温较高,新鲜切开的西瓜滋生细菌量较高,因此检测 … [详情]

















